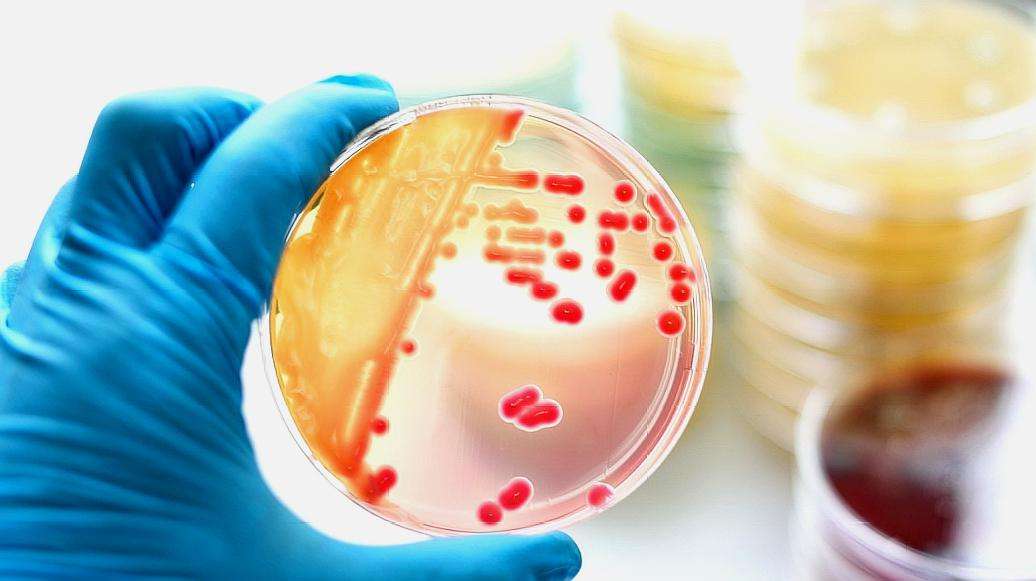
核糖核酸|这是一个好消息！中国研究取得重大发现，不接种新冠疫苗也没事

核糖核酸|这是一个好消息!中国研究取得重大发现,不接种新冠疫苗也没事

文章图片
文章图片

新冠病毒肆虐的2020年 , 对于绝大多数国家来讲 , 都是灾难的一年 。 新冠是人类有史以来遇到的最狡猾难缠的病毒之一 , 至今没有研发出特效药或者疫苗 。 但是眼下希望来了 , 中国研究取得了重大发现 。 据环球时报报道 , 通过动物实验 , 研发人员发现在鼻腔中滴入疫苗也同样能抵抗病毒伤害 , 甚至效果可能比接种来得更有效 。 这是一个天大的好消息 , 也意味着人们不接种新冠疫苗也没事 , 用鼻腔滴入的方式也同样能起到作用 。
鼻腔接种疫苗
来自广州医科大学的研发团队发现了这一令人欣喜的研究结果 。 他们采用一种疫苗在恒河猴身上进行了实验 , 实验结果显示 , 鼻腔滴入疫苗同样可以起到阻隔病毒的作用 , 因为研发人员没有在被试猴子的身上发现新冠病毒的踪迹 。 相反没有接受疫苗注射的猴子身上发现了大量病毒的存在 。 发现这一结论的还不止中国一家科研团队 。 美国华盛顿大学的科研人员 , 也进行了类似实验 , 他们的实验结果和中方得出了相同的结论 , 有力地佐证了滴鼻这种接种方式的确是安全并有效的 。
此外华盛顿的医学团队还进一步发现 , 滴鼻这种方式要比传统的注射要来的效果好 。 这么说的依据是 , 他们在用传统方式接种疫苗的老鼠身上发现了新冠病毒的RNA , 虽然被发现的RNA是没有感染性的 , 但是能证明仍然有少量病毒入侵了 。 但是使用滴鼻方式接种疫苗的老鼠身上 , 没有发现RNA 。 这个结论是在是令人欣喜 , 大家原本以为接种疫苗的方法只有一个 , 那就是注射 。 这种方法比较麻烦 , 需要专业医护人员的操作 。 但没想到 , 科研人员们发现了一个更好的办法 , 只需要把疫苗滴入自己的鼻子就行了 。
关于疫苗接种方式的研究还在进行 , 科研人员又有了新成果 。 他们发现 , 鼻腔滴入的办法可能会改善腺病毒载体本身的缺陷 , 这种缺陷会让疫苗的效果变差 。 更换了新的接种方式之后 , 可以显著的提高疫苗的威力 , 当然现有的实验数据还不足以支撑这个结论 , 要想证实它 , 还需要更多的临床试验数据 。 但可以确定的是 , 鼻腔滴入已经成为了一种备选的接种方式 。 在三期疫苗实验完成后 , 疫苗正式获得批准之后 , 我们很可能会见到鼻腔滴入的疫苗进入大范围的应用 。
有望击败新冠
这一重大发现 , 让人类距离打败新冠病毒的胜利之日又进了一步 。 在关于新冠病毒的研究中 , 英国的一家医疗团队曾经发现 , 新冠抗体无法长久地在人体内存在 。 他们在对康复患者的追踪中发现了这一结论 , 这些患者体内的抗体浓度随着时间下降 。 这个研究结果一度引起了恐慌 , 这意味着 , 即使有疫苗也无法一劳永逸的抵抗病毒 , 可能需要重复接种 。
【核糖核酸|这是一个好消息!中国研究取得重大发现,不接种新冠疫苗也没事】如果能把滴鼻接种应用到实践中去 , 就能解决重复接种麻烦的问题 , 因为大家在家就能给自己接种疫苗 , 不需要专业人员参与 , 大大降低了成本 , 提高了接种效率 。 传统的接种方式往往需要到专业的医疗机构中注射 , 由于注射接种对技术要求高 , 还需要配备很多医生 , 这就限制了接种的速度和范围 。 由此看来 , 这种接种方法的经济效益不可忽视 , 期待科研人员的后续研究 。
- 京东|2.9元一个电水壶,“羊毛党”一天狂刷20万单,京东店家面临破产
- 蜘蛛|它用4.5亿年时间证明:只要成为一个废物,就没人能利用自己
- 莫妮卡·贝鲁奇|一个看似普通的实验,却得到不可能的答案,甚至让人怀疑宇宙
- 基因|偏远山村一群人爬行走路,这是什么情况?人类又退化了?
- 佳德智诚|佳德智诚:客服是影响店铺销量的重要因素
- 阿卡波糖|科学家研究发现,阿卡波糖可延长22%寿命,这是种什么物质?
- 1号纪实|任正非为何经常一个人在机场等出租车?看完这篇文章就知道了
- 太阳系|太阳系外是什么?科学家发现,一个半径1光年的云团在保护人类!
- 电子商务|“电商大战”JDG彻底输了,SN老板发话:爽!双十一给大家一个亿
- 小逗传媒郁雯|却因好色被儿子取了性命,他本来可以成为一个非常厉害的国君
